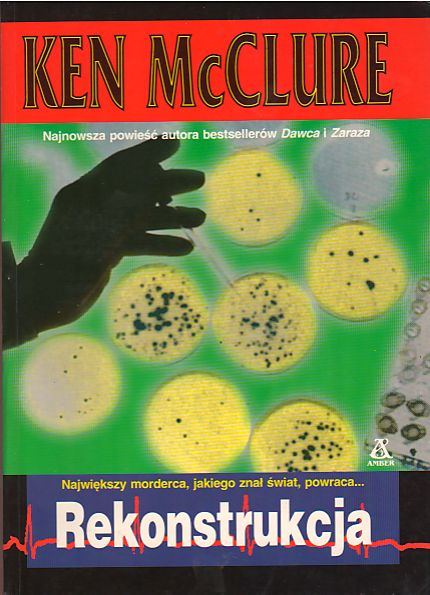

Rekonstrukcja
| Autor: | Ken McClure ... |
|---|---|
| Tłumacz: | Marek Mastalerz |
| Wydawca: | Wydawnictwo Amber Sp. z o. o (1999-2001) |
| Wydane w seriach: | Thriller medyczny |
| ISBN: | 978-83-7245-033-3 |
| Autotagi: | druk literatura |
| Więcej informacji... | |
|
3.0
|
|
|
|
|
Wypożycz w bibliotece
Kup
Recenzje
Opis
| Autorzy: | Ken McClure Ken nazwisko Begg Ken Begg Ken nazwa Begg |
|---|---|
| Tłumacz: | Marek Mastalerz |
| Wydawca: | Wydawnictwo Amber Sp. z o. o (1999-2001) |
| Serie wydawnicze: | Thriller medyczny |
| ISBN: | 978-83-7245-033-3 |
| Autotagi: | druk epika książki literatura literatura piękna powieści |
Powyżej zostały przedstawione dane zebrane automatycznie z treści
8 rekordów bibliograficznych,
pochodzących
z bibliotek lub od wydawców. Nie należy ich traktować jako opisu jednego konkretnego wydania lub przedmiotu.
z bibliotek lub od wydawców. Nie należy ich traktować jako opisu jednego konkretnego wydania lub przedmiotu.